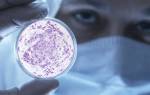

В нашем организме живут миллионы бактерий — их общий вес составляет около двух килограммов. Кишечная палочка занимает среди них далеко не последнее место. Эта бактерия может долгое время помогать человеку в формировании микрофлоры и пищеварении, а может в один момент превратиться в серьезную медицинскую проблему. В нашей статье мы расскажем о способах выявления кишечной палочки.
Кишечная палочка, или Escherichia coli (Эшерихия коли) — это палочковидная бактерия, которая обитает в кишечнике человека и некоторых животных. Существует более сотни разновидностей этой палочки. Большинство из них совершенно безвредны, но некоторые могут вызвать серьезные заболевания.
У здорового человека Escherichia coli живет в толстом кишечнике. Ее количество обычно составляет 104–1010 КОЕ в 1 мл содержимого. В кишечнике эта бактерия участвует в переваривании пищи, синтезирует нужные нам витамины, а также производит органические кислоты. Эти кислоты создают благоприятную среду для развития лакто- и бифидобактерий.
Чаще всего кишечная палочка попадает в другие органы при нарушении гигиены или при снижении иммунитета. Попадая в женскую половую систему, она вызывает кольпит, аднексит, другие воспалительные заболевания. Особенно опасно заражение при беременности и после родов. Это может вызвать внутриутробную инфекцию у ребенка и стать причиной послеродового эндометрита у матери. Мужчин эта опасность тоже не обходит стороной. Кишечная палочка, попавшая в уретру, может вызвать уретрит, простатит, воспаление придатков и яичек.
Кроме этого, нормальная кишечная палочка может мутировать и становиться действительно опасной. Некоторые виды этой бактерии, например O157:H7, O104:H4, O121 и O104:H21, выделяют сильные токсины. Они могут вызвать гемолитико-уремический синдром, перитонит, пневмонию, пищевые отравления.
Чаще всего мутировавшая кишечная палочка попадает в организм вместе с продуктами питания, такими как немытые овощи, плохо обработанное мясо, молоко. Но в некоторых случаях такие штаммы могут образоваться внутри организма в результате мутаций и обмена генами.
Патогенная кишечная палочка нередко вызывает диарею. Обычно эшерихиозом страдают дети младшего возраста и люди, путешествующие в страны с низким уровнем гигиены (так называемая диарея путешественников). Вовремя проведенный анализ позволит выявить кишечную палочку и начать лечение.
Некоторые опасные штаммы кишечной палочки могут вызвать гемолитико-уремический синдром (ГУС). Это тяжелое состояние, при котором в мелких сосудах образуется большое количество тромбов, собственные эритроциты разрушаются и возникает полиорганная недостаточность — тяжелая стресс-реакция организма. При любом подозрении на ГУС обязательно проводят анализ на энтеропатогенные (опасные) эшерихии.
Обычный бактериологический анализ, который проводят при воспалительных заболеваниях органов половой системы, послеродовых эндометритах и других, — также может показать наличие кишечной палочки.
Еще одним показанием к проведению исследования является дисбактериоз. Изменение состава микрофлоры кишечника может привести к проблемам с пищеварением, к урчанию и болям в животе. Нарушение образования витаминов и повышенное всасывание токсинов приводит к слабости, утомляемости и другим неспецифическим симптомам.
Кишечную палочку можно обнаружить в кале, в моче, в мазках с поверхности половых органов или из ран, при посеве промывных вод. Также во время исследований она может быть обнаружена в ране, в легких.
Основным методом анализа для обнаружения кишечной палочки является бактериологический посев. Для этого небольшое количество материала помещают в питательную среду, на которой бактерии очень хорошо размножаются. Результат подсчитывают через несколько дней по количеству образовавшихся колоний. Единица измерения — КОЕ/мл, то есть количество бактерий, из которых при исследовании выросли колонии, в миллилитре материала.
Также существует метод ПЦР-диагностики. Он позволяет сказать, присутствует ли в материале патогенная кишечная палочка. Но ни количество бактерий, ни их чувствительность к лекарственным препаратам этот метод не покажет.
Другие методы, которые не подразумевают выделение чистой культуры кишечной палочки, могут сказать о заражении только косвенно. Например, в общем анализе мочи могут обнаружить бактерии в виде палочек. Но для того чтобы определить их вид придется сдавать дополнительно бактериологический посев. Похожая ситуация и с копрограммой. Анализ может дать представление о состоянии желудка и кишечника, но не позволяет выявить конкретные бактерии.
Общий анализ крови позволяет выявить характерные для воспалительных заболеваний сдвиги. Но они могут быть вызваны не только эшерихиозом, но и дизентерией, пневмонией или любым другим воспалительным заболеванием.
Любое бактериологическое исследование нужно проводить до начала лечения антибиотиками. В противном случае можно получить ложноотрицательный результат.
Анализ кала на кишечную палочку собирается в стерильную пробирку с транспортной средой. Для этого нужно заранее подготовить судно или другую емкость, тщательно вымыть ее и ополоснуть кипятком. В эту емкость собирается кал после естественной дефекации. Из специальной пробирки с транспортной средой нужно достать аппликатор, погрузить его в несколько участков собранного биоматериала и снова убрать в пробирку, плотно закрыв крышку. Если в собранном материале присутствуют кишечные палочки, бактериологический анализ это покажет.
Анализ мочи на бактериологическое исследование тоже собирают в специальную стерильную емкость. Собрать материал можно в любое время суток. Перед этим обязательно нужно принять душ, чтобы в емкость не попали бактерии с поверхности кожи. Чем скорее получится доставить материал в лабораторию, тем лучше.
Мазки и соскобы урогенитального тракта при подозрении на уретрит, вагинит и любые другие мочеполовые заболевания, вызванные кишечной палочкой, забирают сразу в лаборатории или на приеме врача. Специальной щеточкой делается соскоб из уретры, со стенок влагалища или с шейки матки. Это не очень приятная процедура, но без нее не обойтись.
Быстрый анализ, который позволяет выявить в материале ДНК кишечной палочки, проводится за 1–2 рабочих дня. Результат бактериологического анализа на кишечную палочку придется ждать дольше — от 5 до 7 дней. За это время выращивается культура клеток, определяется их вид, проводится анализ на чувствительность к антибиотикам и бактериофагам.
В норме кишечной палочки не должно быть нигде, кроме толстого кишечника. То есть если вы сдаете мочу или мазок, то лучший результат — это отрицательное заключение. Если речь идет о содержимом кишечника, то здесь не должно обнаруживаться энтеропатогенных кишечных палочек, таких как O157:H7. В некоторых лабораториях проводят быстрый ПЦР-тест на целую группу таких бактерий.
При определении чувствительности к антибиотикам или бактериофагам выдается бланк, на котором напротив каждого наименования написана степень влияния препарата на рост бактерии. По такому бланку врач за несколько минут подберет наиболее эффективный для конкретного случая антибиотик.
Анализ на эшерихиоз можно сдать как в обычной поликлинике, так и в частной лаборатории. Желательно заранее уточнить, какой метод исследования при этом используется.
Бактериологические исследования лучше проводить в клиниках и лабораториях, оснащенных автоматическими и полуавтоматическими анализаторами. Это исключает человеческий фактор, позволяет проводить исследование с широким перечнем антибиотиков и бактериофагов. Такие оснащенные лаборатории имеют как современные государственные больницы, занимающиеся лечением инфекционных болезней, так и частные медицинские центры.
Также стоит обратить внимание на время проведения исследования. Для бактериологического исследования это не менее пяти дней. Раньше бактерия просто не успеет вырасти в достаточном для анализа количестве. Время больше 7–10 дней говорит о том, что исследование будет проводиться в сторонней лаборатории. Это существенный недостаток, поскольку речь идет о транспортировке биоматериала, что нежелательно: чем раньше был доставлен материал, тем более достоверным будет результат.
Кишечная палочка — неотъемлемая часть микрофлоры кишечника. Пока она находится под контролем организма, ее клетки помогают синтезировать витамины, переваривать пищу, создавать благоприятную среду для жизни других полезных микробов. Но любое нарушение этого равновесия грозит патологиями вплоть до серьезных воспалительных заболеваний. К счастью, медицина помогает нам вовремя выявить отклонения от нормы и приять соответствующие меры.
Кишечная палочка считается одним из самых распространенных бактерий. Область ее обитания – кишечник человека и некоторых животных. Считается, что после попадания в окружающую среду (бактерия выводится из организма вместе с каловыми массами), она может в течение длительного периода сохранять свою жизнеспособность даже под воздействием внешних факторов.
Бактерии рода кишечной палочки могут быть как безопасными для организма человека, так и патогенными, способными привести к развитию многочисленных заболеваний. Для этих патологий характерны свои ярко выраженные симптомы. При их появлении человеку необходимо срочно обратиться в медицинское учреждение, иначе недуг, вызванный возбудителем, может привести к развитию серьезных осложнений, жизненно-опасных для человека.
Характеристика микроорганизма
Кишечная палочка представляет собой бактерию рода Escherichia из семейства Enterobacteriaceae. Данный микроорганизм активно размножается в человеческом организме, в частности, в различных отделах кишечника. Попадая вместе с каловыми массами в окружающую среду, бактерия может на протяжении нескольких месяцев сохранять свою жизнеспособность. Активная микрофлора содержится в воде, почве, кале, а также в некоторых продуктах питания (особенно, в молоке, мясе).
Кишечную палочку принято разделять на непатогенную и патогенную. Представители нормальном микрофлоры, обитающие в кишечнике, оказывают ряд полезных для организма действий. Прежде всего, данные микроорганизмы нормализуют кишечную микрофлору, подавляя рост вредных бактерий. Кроме того, они синтезируют витамин К, необходимый для поддержания нормального процесса свертываемости крови и выполнения других важных функций в организме.

Некоторые из представителей данного вида способны выделять ферменты, расщепляющие лактозу. Однако, безопасными данные бактерии остаются лишь тогда, когда они находятся в полости кишечника. При проникновении в другие органы, непатогенная микрофлора может спровоцировать развитие воспаления.
Классификация и виды бактерий
Бактерии группы кишечной палочки могут быть безопасными и патогенными. В свою очередь, непатогенная микрофлора может быть лактозопозитивными (в большинстве случаев), то есть способными расщеплять лактозу, либо лактозонегативными, не имеющими такой способности.
Патогенные микроорганизмы принято разделять на следующие виды:
- Энтерогеморрагическая кишечная палочка – группа бактерий, приводящая к развитию диареи и кишечных кровотечений;
- Энтеропатогенная – бактерии данного вида негативно воздействуют на эпителиальный слой кишечника, разрушая его ворсинки. Результатом такого воздействия становится продолжительное нарушение стула и метаболических процессов;
- Энтероинвазивная – микроорганизмы внедряются в ткани кишечных стенок, что приводит к развитию выраженного очага воспаления.

Причины и пути передачи
Необходимо понимать, какие причины способствуют проникновению патогенной кишечной палочки в организм и ее активизации (размножению) в кишечнике. К числу таких причин относят:
- Нарушение микрофлоры кишечника, в частности, массовая гибель полезных микроорганизмов в результате заболеваний ЖКТ;
- Патологии поджелудочной железы;
- Воспаления в кишечнике;
- Длительное употребление антибактериальных препаратов (несмотря на то, что данная лекарственная группа предназначена именно для борьбы с патогенной микрофлорой, бесконтрольный прием антибиотиков может привести к обратной ситуации: бактерии приспосабливаются к действию лекарства и теряют чувствительность к его активным веществам. В результате этого происходит усиленный рост численности вредной микрофлоры);
- Несоблюдение правил личной гигиены;
- Употребление зараженных продуктов питания и воды.
Кишечная палочка, относящаяся к патогенному виду, попадает в организм человека различными способами:
- Через продукты питания. Например, если человек употребляет сырое молоко, мясо, не прошедшее должную термическую обработку, сырое молоко;
- Контактно – бытовой способ, например, при контакте с больным человеком (через немытые руки), при использовании зараженных вещей и предметов обихода;
- Родовой способ, когда бактерия передается новорожденному от больной матери;
- Половой. Во время полового акта кишечная палочка также может проникнуть в организм, хотя происходит это довольно редко.
Характерные симптомы
При активном развитии патогенной кишечной палочки в организме человека, появляются специфические симптомы, такие как потеря аппетита, диарея, тошнота и рвота, болезненные ощущения в различных отделах живота. При этом меняется структура, цвет и запах каловых масс. Кал становится более жидким, водянистым, может приобретать слизистую консистенцию. Цвет его становится более светлым, возможно появление в каловых массах кровянистых прожилок. Кал приобретает более резкий и неприятный запах.
У больного наблюдается обильное отхождение рвотных масс. При этом рвота приобретает специфический зеленый оттенок и резкий запах. У пациента отмечается выраженная слабость, отсутствие работоспособности, головокружения. В тяжелых случаях развивается нарушение жидкостного баланса организма со всеми характерными для данного состояния симптомами (бледность, сухость эпидермиса и наружных слизистых оболочек, слабость, постоянная жажда).
Стадии и проявления
Клинические признаки развития опасных заболеваний, возбудителем которых является кишечная палочка патогенного типа, зависят от давности проникновения болезнетворной микрофлоры в кишечник, а также от количества бактерий и продуктов жизнедеятельности, выделяемых ими. В соответствии с этими параметрами, выделяют 3 стадии развития патологического процесса. Для каждой из них характерен свой набор признаков.
| Этап | Проявления и симптомы |
| Начальная стадия патологии, когда в организме человека наблюдается незначительное количество патогенной микрофлоры. | Симптомы и проявления патологического процесса носят умеренный характер. Больного беспокоит периодически появляющаяся слабость, умеренная диарея (или запор), чувство распирания в животе, возникающее через некоторое время после приема пищи. |
| Этап развития, во время которого увеличивается рост численности патогенных микроорганизмов, полезные бактерии, напротив, начинают отмирать. | Возникает выраженное расстройство желудка, сопровождающееся обильным выделением каловых масс, которые теперь имеют водянистую или слизистую консистенцию. Во время акта дефекации пациент испытывает тянущую боль внизу живота. Усиливается рвота. Пациент теряет аппетит, его самочувствие ухудшается в значительной степени. Имеет место повышение температуры, озноб. |
| Завершающая стадия. | На данном этапе симптомы имеют наиболее выраженную характеристику. В тяжелых случаях развивается кровавая диарея, обезвоживание, рвотные массы приобретают зеленый цвет. В этом случае пациенту необходима экстренная госпитализация. |
При нормальном течении патологического процесса происходит постепенное самоочищение кишечника, после чего наступает улучшение.
Осложнения и заболевания
Патогенная форма кишечной палочки может приводить к развитию весьма неприятных последствий, заболеваний, значительно нарушающих самочувствие человека, несущих реальную угрозу для его здоровья. У женщин кишечная палочка, проникающая в область уретры или влагалища, может привести к таким патологиям как кольпит, уретрит. Частыми заболеваниями, возникающими у представительниц прекрасного пола, являются цистит, эндометрит, пиелонефрит, аднексит. Также возникают различные неприятные симптомы, такие как сильный и болезненный зуд во влагалище, творожистые, резко пахнущие выделения из половых органов.
У мужчин развиваются такие патологии как обильная диарея, токсическое поражение организма, сопровождающееся рвотой, ухудшением общего состояния. Возможно развитие следующих заболеваний: простатит, орхит, эпидидимит, пиелонефрит, воспаление тканей мочевого пузыря и нарушение его функциональности (анурия, энурез).
Особенно опасной патогенная кишечная палочка считается для детей. У зараженного ребенка наблюдается значительная гипертермия, сильный и зловонный понос, потеря аппетита и массы тела, признаки обезвоживания, истощения. Нарушается работа иммунной системы. Появляются области нагноения, которые могут привести к токсическому заражению крови и внутренних органов.
Методы диагностики
Для того, чтобы назначить подходящее лечение, необходимо поставить точный диагноз. Для этого используют различные диагностические мероприятия. Прежде всего, врач проводит беседу с пациентом, устанавливает совокупность симптомов и жалоб, беспокоящих больного, длительность и обстоятельства их появления. После этого больному назначают различные лабораторные и инструментальные обследования.
Инструментальные способы диагностики необходимы для того, чтобы выявить поражения кишечника и других органов (почки, желчный пузырь). Использование таких методов необходимо не всегда, а только в том случае, если имеются симптомы соответствующих заболеваний.
Для выявления патологического процесса большое значение имеют именно лабораторные методы исследования, позволяющие не только выявить нарушения микрофлоры, но и определить конкретного возбудителя инфекции, оценить степень его чувствительности к тем или иным антибактериальным веществам. Это необходимо для выбора подходящей схемы лечения.
- Анализ крови на кишечную палочку. В норме данный микроорганизм в крови не содержится. Если же бактерию обнаруживают, это говорит о том, что здоровье и жизнь человека находятся в опасности, ведь проникновение возбудителя в кровоток может спровоцировать развитие сепсиса (заражения крови) – жизненно-опасного состояния, способного привести к летальному исходу.
- Исследование мочи. Обнаружение возбудителя в моче говорит о заражении органов мочевыделительной системы и необходимости срочной антибактериальной терапии. О стадии развития заражения судят по количеству бактерий, имеющимся признакам;
- Мазок из влагалища. В норме кишечная палочка в мазке отсутствует. Если же она обнаружена, это свидетельствует о заражении органов репродуктивной системы;
- Исследование кала. При развитии кишечной палочки данные микроорганизмы в большом количестве присутствуют в каловых массах (в норме содержание этих микроорганизмов допускается, но в значительно меньшем количестве). После того, как возбудитель обнаружен, выполняется процедура бактериального посева. То есть бактерию помещают в особую среду, после чего оценивают дальнейшее ее развитие и размножение. Это позволяет определить тип микроорганизма, его чувствительность к различным видам антибиотиков.
Методы терапии
Лечение патологий, вызванных кишечной палочкой, включает в себя следующие моменты:
- Медикаментозная терапия и прием витаминов для восстановления иммунитета;
- Использование средств – пробиотиков для нормализации кишечной микрофлоры и устранения дисбактериоза;
- Соблюдение особого режима питания.
Медикаментозное лечение предполагает использование лекарственных средств различных групп. Это, прежде всего антибиотики, препараты для устранения воспалений в мочевыводящих органах, органах половой системы, средства, предотвращающие развитие обезвоживания, препараты, восстанавливающие здоровую микрофлору в кишечнике, витаминные препараты для укрепления иммунной системы.
Диета предполагает употребление большого количества кисломолочных продуктов, обогащенных полезными бактериями, овощей и фруктов, нормализующих процесс пищеварения, травяных отваров, обладающих противовоспалительным действием. Запрещено употребление блюд, тяжелых для переваривания и продвижения по пищеварительному тракту. Это жирные и жареные блюда, острые, соленые, сладкие продукты, газированная вода, полуфабрикаты, консервы и колбасные изделия, а также же продукты, вызывающие чувство дискомфорта у конкретного человека.
Читайте также: